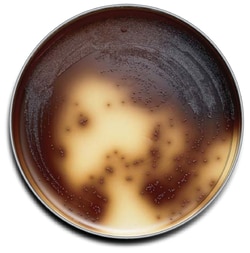

Promotional price valid on web orders only. Your contract pricing may differ. Interested in signing up for a dedicated account number?
Learn More
Learn More
BD BBL™ Prepared Plated Media: Bile Esculin Azide Agar (Enterococcosel™)
Shop All BD Diagnostic Systems Products
Click to view available options
Quantity:
100/Pk.
20/Pk.
For Use With (Application):
Enterococci detection/count
Media Type:
Bile Esculin Azide Agar
Bile Esculin Azide Enterococcosel™ Agar
Specifications
Specifications
| Certifications/Compliance | ISO/DIS, 11014 |
| Color | Yellow Brown |
| Content And Storage | 2 to 25°C |
| Form | Liquid |
| Manufacturing Origin | United States |
| Media Type | Bile Esculin Azide Agar |
| Formulation | Pancreatic digest of Casein 17g/L, Peptic digest of Animal Tissue 3g/L, Yeast extract 5g/L, Oxgall 10g/L, Sodium Chloride 5g/L, Esculin 1g/L, Ferric Ammonium Citrate 0.5g/L, Sodium Azide 0.25g/L, Sodium Citrate 1g/L, Agar 13.5g/L |
| For Use With (Application) | Enterococci detection/count |
| Packaging Type | Plate |
| Quantity | 20/Pk. |
Product Content Correction
Your input is important to us. Please complete this form to provide feedback related to the content on this product.
Product Title
Spot an opportunity for improvement?Share a Content Correction